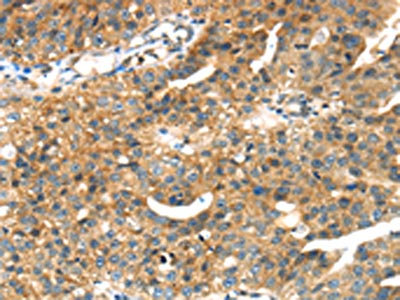

SEPP1 Antibody
-
中文名稱:SEPP1兔多克隆抗體
-
貨號:CSB-PA583633
-
規格:¥1100
-
圖片:
-
The image on the left is immunohistochemistry of paraffin-embedded Human liver cancer tissue using CSB-PA583633(SEPP1 Antibody) at dilution 1/35, on the right is treated with fusion protein. (Original magnification: ×200)
-
The image on the left is immunohistochemistry of paraffin-embedded Human breast cancer tissue using CSB-PA583633(SEPP1 Antibody) at dilution 1/35, on the right is treated with fusion protein. (Original magnification: ×200)
-
-
其他:
產品詳情
-
Uniprot No.:
-
基因名:SELENOP
-
別名:Selenoprotein P antibody; Selenoprotein P plasma 1 antibody; Selp antibody; SeP antibody; Sepp1 antibody; SEPP1_HUMAN antibody
-
宿主:Rabbit
-
反應種屬:Human
-
免疫原:Fusion protein of Human SEPP1
-
免疫原種屬:Homo sapiens (Human)
-
標記方式:Non-conjugated
-
抗體亞型:IgG
-
純化方式:Antigen affinity purification
-
濃度:It differs from different batches. Please contact us to confirm it.
-
保存緩沖液:-20°C, pH7.4 PBS, 0.05% NaN3, 40% Glycerol
-
產品提供形式:Liquid
-
應用范圍:ELISA,IHC
-
推薦稀釋比:
Application Recommended Dilution ELISA 1:2000-1:5000 IHC 1:25-1:100 -
Protocols:
-
儲存條件:Upon receipt, store at -20°C or -80°C. Avoid repeated freeze.
-
貨期:Basically, we can dispatch the products out in 1-3 working days after receiving your orders. Delivery time maybe differs from different purchasing way or location, please kindly consult your local distributors for specific delivery time.
-
用途:For Research Use Only. Not for use in diagnostic or therapeutic procedures.
相關產品
靶點詳情
-
功能:Might be responsible for some of the extracellular antioxidant defense properties of selenium or might be involved in the transport of selenium. May supply selenium to tissues such as brain and testis.
-
基因功能參考文獻:
- When rs13154178 gene polymorphism was compared with AA homozygous individuals, fasting blood glucose levels were significantly higher in carriers of either polymorphism than in those with no polymorphism. We suggest rs13154178 gene polymorphism may lead to gestational diabetes mellitus in the Turkish society. PMID: 29648467
- preliminary result indicated the beneficial effect of serine on the expression of SelP and GPx, which suggested that it might be a candidate for combined selenium supplement. PMID: 26944060
- Genetic variations in selenoprotein genes modulated both GPX1 and SELENOP selenoprotein gene expression and global gene expression in response to Brazil nut supplementation. PMID: 28696394
- SeP was higher in individuals who were overweight/obese, and associated with insulin resistance by HOMA-IR and by clamp, but not independently of BMI. PMID: 27524654
- We have demonstrated a significant decrease in circulating SeP levels according to MetS status in patients with documented cardiovascular disease. PMID: 28190280
- Results indicate a diversity of RNA elements conducting multiple occurrences of UGA redefinition to control the synthesis of full-length and truncated selenoprotein P (SELENOP) isoforms. PMID: 29069514
- Biomarkers of Se status in clinical research need to be measured by validated assays in order to avoid erroneous data and incorrect interpretations, especially when analyzing young women. The Se content of circulating SELENOP differs between individuals and may provide some important diagnostic information on Se metabolism and status PMID: 28064116
- Study suggests the 3' UTR structural elements (SECIS) in Sepp1 functions with site specificity and further illustrates how mRNA processing may produce transcripts with altered coding potential to produce diversity in selenoprotein isoforms. PMID: 27881738
- Increased amounts of circulating SeP predicted the ineffectiveness of training on endurance capacity in humans. PMID: 28263310
- Results indicate that the 2 genetic variants of rs7579 and rs230813 in SEPP1 may not play a role in the pathogenesis of preeclampsia in Chinese Han Women. PMID: 28700468
- erum microRNA-7 and selenoprotein P appear to be potential non-invasive diagnostic markers for hepatocellular carcinoma. Moreover, the results suggest that selenium could be used as an anticancer therapy for hepatocellular carcinoma by affecting both microRNA-7 and selenoprotein P PMID: 28459371
- The selenium levels in the tissues were correlated to the genotype of the SELENOP selenium carrier protein, but not to other proteins whose levels have been reported to be responsive to selenium availability, including GPX1, SELENOF and SBP1. PMID: 27908419
- GPX1 and SEPP1 Single Nucleotide Polymorphism were not associated with any changes in the expression of related genes. GPX1 was shown to modulate the expression of unrelated target, SEP15, upon Se supplementation, both alone and in combination with SEPP1. PMID: 26658762
- Data show that the cell proliferative ability was inhibited in the cells overexpressing selenoprotein P, plasma 1 (SEPP1), and the colony forming ability of The cell evidently decreased. PMID: 27371843
- Selenoprotein P concentrations are not elevated in women with gestational diabetes mellitus but are associated with BMI and HDL cholesterol. PMID: 26514640
- Studied gene-specific regulation of hepatic selenoprotein expression by interleukin-6; by testing human hepatocytes in culture, found IL-6 reduced the concentrations of SePP mRNA and secreted SePP in a dose-dependent manner. PMID: 26399395
- Impaired renal function is positively correlated with serum concentrations of SePP. PMID: 26348725
- women who carry the SEPP1 rs3877899 A allele are better able to maintain selenium status during pregnancy, and their GPx3 activity increases more with supplementation, which suggests better protection from low selenium status. PMID: 26675765
- this study provide preliminary genetic evidence that the SEPP1 functional variants contribute to the AAA risk. PMID: 25395084
- Elevated SeP concentrations are independently associated with a reduced risk of MetS in children PMID: 24638201
- These results demonstrate that SEPP1 represents a previously unrecognized regulator of Polychlorinated biphenyl-induced biological effects. PMID: 23770201
- Selenium, selenoenzymes, oxidative stress and risk of neoplastic progression from Barrett's esophagus: results from biomarkers and genetic variants. PMID: 22715394
- These results demonstrated that SelP interacts with tubulin, alpha 1a (TUBA1A). PMID: 24914767
- data suggest that SEPP1 alters breast cancer risk among women with higher levels of NA ancestry PMID: 24278290
- The histidine-rich domain of selenoprotein P is capable of binding Cu ions in both oxidation states of Cu(+) and Cu(2+) with high affinity and of modulating Cu(+) and Cu(2+)-mediated ABETA aggregation, reactive oxygen species production, neurotoxicity. PMID: 24437729
- Data suggest that plasma SEPP1 level can be up-regulated by dietary factors; here, significantly higher plasma SEPP1 is observed in women at risk of pre-eclampsia treated with dietary supplement of selenium-enriched yeast started in first trimester. PMID: 24708917
- SEPP1 rs7579 was found to be associated with lower risk of advanced prostate cancer. PMID: 24563517
- This study demonistrated that Sepp1 in midbrain was expressed in neurons of the substantia nigra (SN), and expression was concentrated within the centers of Lewy bodies, the pathological hallmark of Parkinson disease PMID: 23268326
- The data provide evidence that single nucleotide polymorphisms in SEPP1 and GPX1 modulate risk of breast cancer. PMID: 24039907
- SePP is not only involved in Selenium transport to testes supporting GPX4 biosynthesis but it also becomes secreted into seminal plasma. PMID: 24361887
- metformin decreases binding of FoxO3a, a direct target of AMPK, to the SEPP1 promoter. PMID: 24257750
- Sepp1 secreted from epithelial cells may support the intestinal immune system by providing immune cells (including plasma cells) with selenium PMID: 24157689
- We speculate that there could be a feedback regulation between hepatic Sepp1 and pancreatic insulin and that increased circulating Sepp1 might be the result rather than the cause of abnormal glucose metabolism.[Review] PMID: 23760059
- Genetic variants in selenoprotein P plasma 1 gene (SEPP1) are associated with fasting insulin and first phase insulin response in Hispanics PMID: 24161883
- SEPP1 genetic variation was associated with prostate cancer incidence; replication of these results in an independent dataset is necessary. PMID: 23129481
- Higher tumor grade and tumor stage at diagnosis correlated to lower SePP and Se concentrations. PMID: 23056383
- hepatocellular SAM-dependent protein methylation is required for both SEPP1 and gluconeogenic enzyme expression and that inhibition of protein arginine methylation might provide a route to therapeutic interventions in type II diabetes. PMID: 22932905
- Circulating selenoprotein P levels were positively correlated with fasting plasma glucose and negatively associated with both total and high-molecular adiponectin in type 2 diabetics. PMID: 22496878
- Circulating SeP concentrations were elevated in patients with glucose metabolism dysregulation and were related to various cardiometabolic parameters including insulin resistance, inflammation, and atherosclerosis. PMID: 21677040
- The glucocorticoid receptor inhibits selenoprotein P transactivation via response elements; the finding provides insight into a potential mechanism of selenium redistribution during development. PMID: 19513589
- Selenoprotein P levels in prostate cells determine basal reactive-oxygen-species levels and H2O2-induced cytotoxicity. Deregulation of selenoprotein P during prostate carcinogenesis may increase free radicals, thus promoting tumor development. PMID: 21456065
- Using serial analysis of gene expression and DNA chip methods, the study found that hepatic SeP mRNA levels correlated with insulin resistance in humans. PMID: 21035759
- tear SeP is a key molecule to protect the ocular surface cells against environmental oxidative stress PMID: 20360971
- Inflammation of the intestinal mucosa causes a decline in locally produced selenoprotein P in the colon that eventually may contribute to the emergence of inflammatory bowel disease-related colorectal cancer. PMID: 20542496
- The present results show no significant difference in genotype and allele distribution of SNP r25191g/a between individuals with Kashin-Beck disease and controls. PMID: 20565998
- These findings suggest an association between the individual selenoprotein concentration and the presence of diabetes. PMID: 20875901
- Our findings demonstrate that Selenoprotein P protects neuronal cells from amyloid beta-induced toxicity, suggesting a neuroprotective role for SelP in preventing neurodegenerative disorders. PMID: 20521393
- Early decrease in Sel-P plasma concentrations was specifically observed in septic shock and was similar in SIRS patients whereas GPx activity remained unchanged. PMID: 19779296
- A DNA-repeat structure within the promoter contains a functionally relevant polymorphism and is genetically unstable under conditions of mismatch repair deficiency PMID: 12173025
- selenoprotein P functions as a Se-supply protein, delivering Se to the cells PMID: 12423375
顯示更多
收起更多
-
亞細胞定位:Secreted.
-
蛋白家族:Selenoprotein P family
-
組織特異性:Made in the liver and heart and secreted into the plasma. It is also found in the kidney.
-
數據庫鏈接:
Most popular with customers
-
-
YWHAB Recombinant Monoclonal Antibody
Applications: ELISA, WB, IHC, IF, FC
Species Reactivity: Human, Mouse, Rat
-
Phospho-YAP1 (S127) Recombinant Monoclonal Antibody
Applications: ELISA, WB, IHC
Species Reactivity: Human
-
-
-
-
-